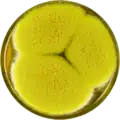
Aspergillus bertholletius growing on MEAOX plate

Aspergillus bertholletius
| Aspergillus bertholletius | |
|---|---|
| Scientific classification | |
| Kingdom: | Fungi |
| Division: | Ascomycota |
| Class: | Eurotiomycetes |
| Order: | Eurotiales |
| Family: | Aspergillaceae |
| Genus: | Aspergillus |
| Species: | A. bertholletius
|
| Binomial name | |
| Aspergillus bertholletius Taniwaki, Pitt and Frisvad (2012)[1]
| |
Aspergillus bertholletius is a species of fungus in the genus Aspergillus. It is from the Flavi section.[2] The species was first described in 2012.[1] It has been isolated from Brazil nuts (Bertholletia excelsa).[1]
Growth and morphology
A. bertholletius has been cultivated on both Czapek yeast extract agar (CYA) plates and Malt Extract Agar Oxoid® (MEAOX) plates. The growth morphology of the colonies can be seen in the pictures below.
-
 Aspergillus bertholletius growing on CYA plate
Aspergillus bertholletius growing on CYA plate -
Aspergillus bertholletius growing on MEAOX plate
Aspergillus bertholletius growing on MEAOX plate
References
- ^ a b c Taniwaki, Marta H; Pitt, John I; Iamanaka, Beatriz T; Sartori, Daniele; Copetti, Marina V; Balajee, Arun; Fungaro, Maria Helena P; Frisvad, Jens C (2012). "Aspergillus bertholletius sp. nov. From Brazil Nuts". PLOS ONE. 7 (8): e42480. Bibcode:2012PLoSO...742480T. doi:10.1371/journal.pone.0042480. PMC 3428331. PMID 22952594.
- ^ Carvajal-Campos, Amaranta; Manizan, Ama; Tadrist, Souria; Akaki, David; Koffi-Nevry, Rose; Moore, Geromy; Fapohunda, Stephen; Bailly, Sylviane; Montet, Didier; Oswald, Isabelle; Lorber, Sophie; Brabet, Catherine; Puel, Olivier (2017). "Aspergillus korhogoensis, a Novel Aflatoxin Producing Species from the Côte d'Ivoire". Toxins. 9 (11): 353. doi:10.3390/toxins9110353. PMC 5705968. PMID 29088078.